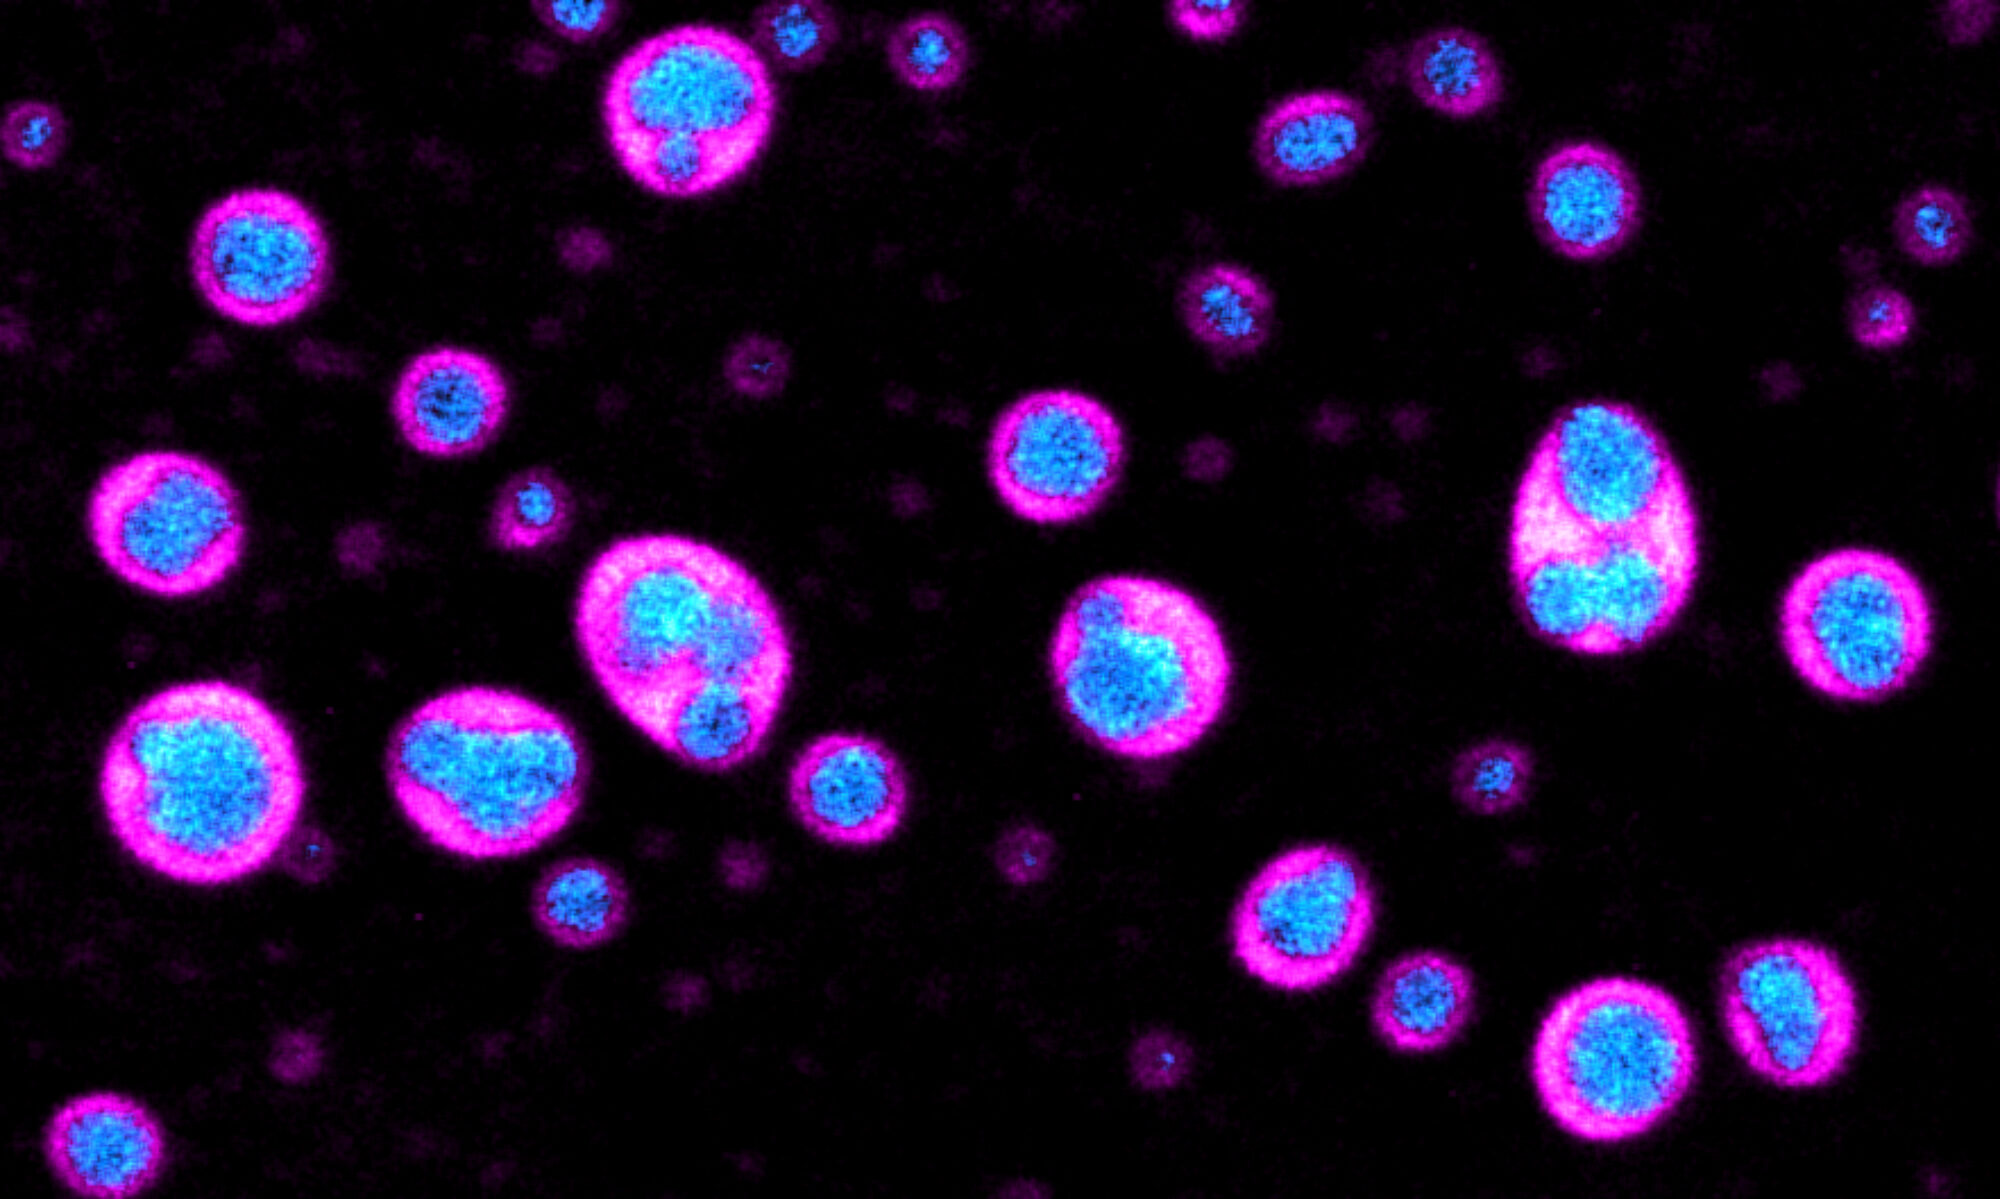

Supramolecular materials are materials formed via the self-assembly of molecules driven by non-covalent interactions. Prominent examples are liquid crystals in LCDs, amphiphiles in drug delivery vehicles, and peptide scaffolds that are used in regenerative medicine. As supramolecular chemists, we are developing more and more successful examples of these materials. However, somehow we do not manage to create materials as elegant as biology does. Biological materials, like skin or bone, are also formed via self-assembly. However, these materials can self-heal, regenerate, are organized on multiple length scales, and are controlled over space and time. What are we doing wrong?
One difference between synthetic supramolecular materials and biological materials is their position in the energy landscape. Supramolecular materials are typically made such that they reside in, or close to, equilibrium. That means that the material is not exchanging energy or matter with its environment. Practically, that means the materials are stable and will be so for the coming years. That is very different in the case of biology. Living materials are not stable, but require the constant input of energy. That may sound complicated, but it does offer a whole range of new material properties.
The aim of this work is thus to develop supramolecular materials that are, like living materials, sustained by chemical reactions. We call them chemically fueled supramolecular materials. These materials are designed to be intrinsically unstable, which means that these materials can only be sustained by a constant supply of chemical fuel.
In this work, we study how to create chemically fueled supramolecular materials, and we study their unique material properties. One of these properties is their spatiotemporal control; that means, these materials can be controlled over space and time by kinetic parameters such as the concentration of reagents. We demonstrate this feature with self-erasing inks below. Where we apply our reagents, the supramolecular ink emerges. However, due to its intrinsically unstable nature, the ink self-erases with a tuneable lifetime.
Our research in this field has led to the following publications:
L. Tebcharani, et al. Emulsions of hydrolyzable oils for the zero-order release of hydrophobic drugs, J. Controlled Release (pdf)
C. Wanzke et al. Emulsions of active droplets release drugs with a constant and tunable rate
Materials Horizons (pdf)
B. Rieß et al. Applications of dissipative supramolecular materials with a tunable lifetime
ChemNanoMat (pdf)
M. Tena-Solsona,et al. Non-equilibrium dissipative supramolecular materials with a tunable lifetime Nature Commun. (pdf)